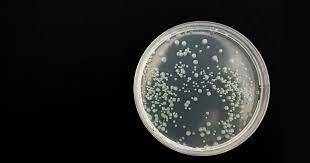
Cultivo selectivo de bacterias

-
 Edward Jenner,
Edward Jenner, -
 Horace Wells
Horace Wells -
 John Snow
John Snow -
Robert Koch
Robert Koch -
 Wilhelm Roentgen
Wilhelm Roentgen -
 Mathieu Jaboulay publicó el primer trasplante realizado en un ser humano
Mathieu Jaboulay publicó el primer trasplante realizado en un ser humano -
 Científicos de la Universidad de Toronto
Científicos de la Universidad de Toronto -
Alexander Fleming
-
 Harold Ridley
Harold Ridley -
 Sistema robótico Da Vinci
Sistema robótico Da Vinci
Looking for a timeline maker?
Create timelines for projects, roadmaps, history, lessons, legal cases, and stories with Timetoast. Timetoast is a timeline maker for work, school, research, and stories.
